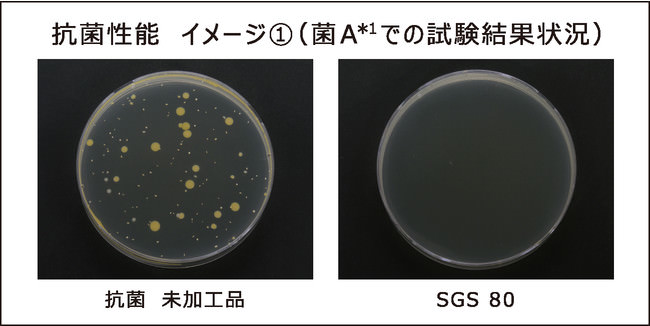
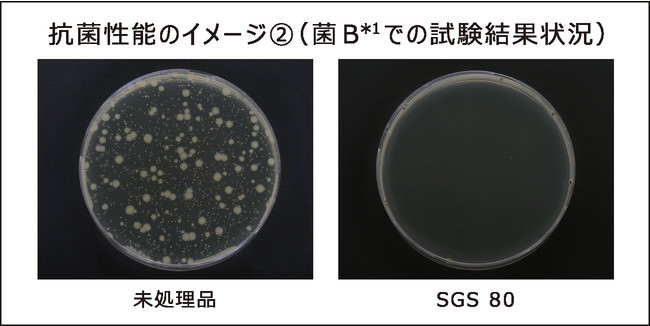

株式会社ユポ・コーポレーションのプレスリリース
株式会社ユポ・コーポレーション(代表取締役社長 渡邉真士、本社:東京都千代田区神田駿河台、以下「当社」)は、医療現場で使用する医薬品ラベルや、食品ラベル等を主用途とする当社製品「ユポタック原紙SGS80」「ユポタック原紙SGSG80」で、抗菌SIAAマーク認証(一般社団法人 抗菌製品技術協議会)を取得いたしました。本製品は、抗菌性及び安全性における信頼の抗菌SIAAマーク認証を取得した国内初の印刷・ラベル原紙用合成紙となります。


*画像はイメージです。
当社は、日頃からお客様目線での用途開発・品質向上に努めており、生活者ニーズを反映した研究開発・改善に取り組んでいます。本認証取得の背景には、世界的な抗菌、抗ウイルスニーズの高まりから、既存製品における当該性能有無に関して、外部評価(SIAA認定のJNLA登録試験業者/一般財団法人ボーケン品質評価機構)を実施し、「SGS 80」、「SGSG 80」の2製品で抗菌性*及び安全性を確認しました。
この度、適正で安心できる抗菌・防カビ加工製品の普及を目的として活動する、一般社団法人 抗菌製品技術協議会による、抗菌SIAAマーク認証を取得いたしました。当社では、企業理念に定める「人々のより良いくらしを実現する」という使命に基づき、今後も研究開発、製品ラインナップ拡充に取り組んでまいります。
*抗菌性は印刷面に付与されます。
■「ユポタック原紙SGS80、SGSG80」の特長(https://japan.yupo.com/product/category/label/)
本来のラベル原紙としての適性に加えて、
・信頼の抗菌SIAAマーク認証を取得、SIAAに登録された国内初ラベル原紙用合成紙
・製品表面(粘着加工品含む)に付着した細菌の増殖を100分の1以下に抑制
・SIAA(一般社団法人 抗菌製品技術協議会)が独自に定める安全性基準に適合
・人の皮膚付着時も安全性に問題なし*2021 年8 月、株式会社きれいテストラボで「ヒト皮膚貼付試験(48 時間閉鎖式)」にて人体における皮膚付着時の安全を確認※「ユポタック」は㈱ユポ・コーポレーションの登録商標です。
<抗菌性能について/当社製品の評価結果>
・抗菌SIAAマークの基準:抗菌加工品の表面上に付着した細菌の増殖割合が、抗菌未加工品の表面と比較し、100分の1以下。
測定日 :2021年4月21日
対象製品:SGS80
評価機関:SIAA認定のJNLA登録試験業者(一般財団法人日本繊維製品品質技術センター)
測定方法:ISO 22196に準拠 ※ISO22196:https://ja.wikipedia.org/wiki/ISO_22196

*1:薬機法(医薬品、医療機器等への品質、有効性及び安全性の確保等に関する法律)
の関係上、特定の菌名が表記できないため 菌A、菌Bと記載しております
*2:上記データは、保証値ではありません。使用場所、気温、日照などの条件により異なります。
*3:製品表面に付着した細菌に効果を発揮します、表面に汚れが付着した状態では効果が
低下することがあります。
<抗菌SIAAマークについて>
SIAAマークはISO22196法により評価された結果に基づき、抗菌製品技術協議会で品質管理
情報公開された製品に表示されています。
・抗菌製品技術協議会(以下、SIAA)が制定した抗菌のシンボルマーク。
・次の3つの基準を満たした製品に、SIAAマークが表示される。
■抗菌性: 抗菌加工されていない製品の表面と比較し、細菌の増殖割合が百分の一以下であり、
耐久性試験後も抗菌効果が確認されること。
■安全性: SIAAが独自に決めた安全性基準を満たしていること。
■適切な表示:抗菌剤の種類、加工部位を明示していること。
<SIAA(一般社団法人 抗菌製品技術協議会)について> https://www.kohkin.net/siaa.html
SIAA(抗菌製品技術協議会)は、適正で安心できる抗菌・防カビ加工製品の普及を目的とし、抗菌剤・防カビ剤
および抗菌・防カビ加工製品のメーカー、抗菌試験機関が集まってできた団体。
業界だけでなく、消費者代表、専門家および行政などの幅広い意見を聞きながら、抗菌加工製品に求められる品質や
安全性に関するルールを整備し、かつそのルールに適合した製品の安心のシンボルSIAAマーク表示を認めている。
<製品概要>
| 製品名 | ユポタック®原紙 | 同左 |
| 型 番 | SGS80 | SGSG80 |
| SIAA登録番号 | JP0123075A0001U | JP0123075A0002V |
| SIAA登録情報 | 有機抗菌剤・表面処理 | 同左 |
| 厚み・坪量 | 80μm | 同左 |
| 製品特徴 | 長年実績のあるスタンダードタイプ | バイオマス樹脂配合「ユポグリーン」シリーズ |
| 印刷方式 | フレキソ印刷、UVオフセット輪転、レタープレス、グラビア印刷に対応 | 同左 |
| 製品用途 | 抗菌性が求められる各種ラベル | 同左 |
| テストサンプル | ご要望の場合はお問合せください。 | 同左 |
| 販売開始 | 販売中 | 同左 |
<導入が見込まれる業界>
・医療業界(医薬品用ラベル)
・食品業界(食品用ラベル)
・家庭用品・日用品業界 他
(化粧品・トイレタリー関連ラベル)

*画像はイメージです。

*画像はイメージです。
<製品名/製品情報サイト>
製品名称 :ユポタック®原紙
情報サイト :https://japan.yupo.com/product/category/label/
<合成紙ユポとは>
ユポは、ポリプロピレン樹脂と無機充填材を主原料とする、水に強く破れにくいフィルム法合成紙です。独自の製法により、ユポは無数の微細な空孔(以下「ミクロボイド」)がその内部に付与されており、このミクロボイドにより、紙の特性である「印刷・筆記適性」、及び「軽量性」を実現しています。これらの特性を活かし、ユポは屋外や水回りで使用されるポスターやラベル等の印刷物として長年使用されています。

